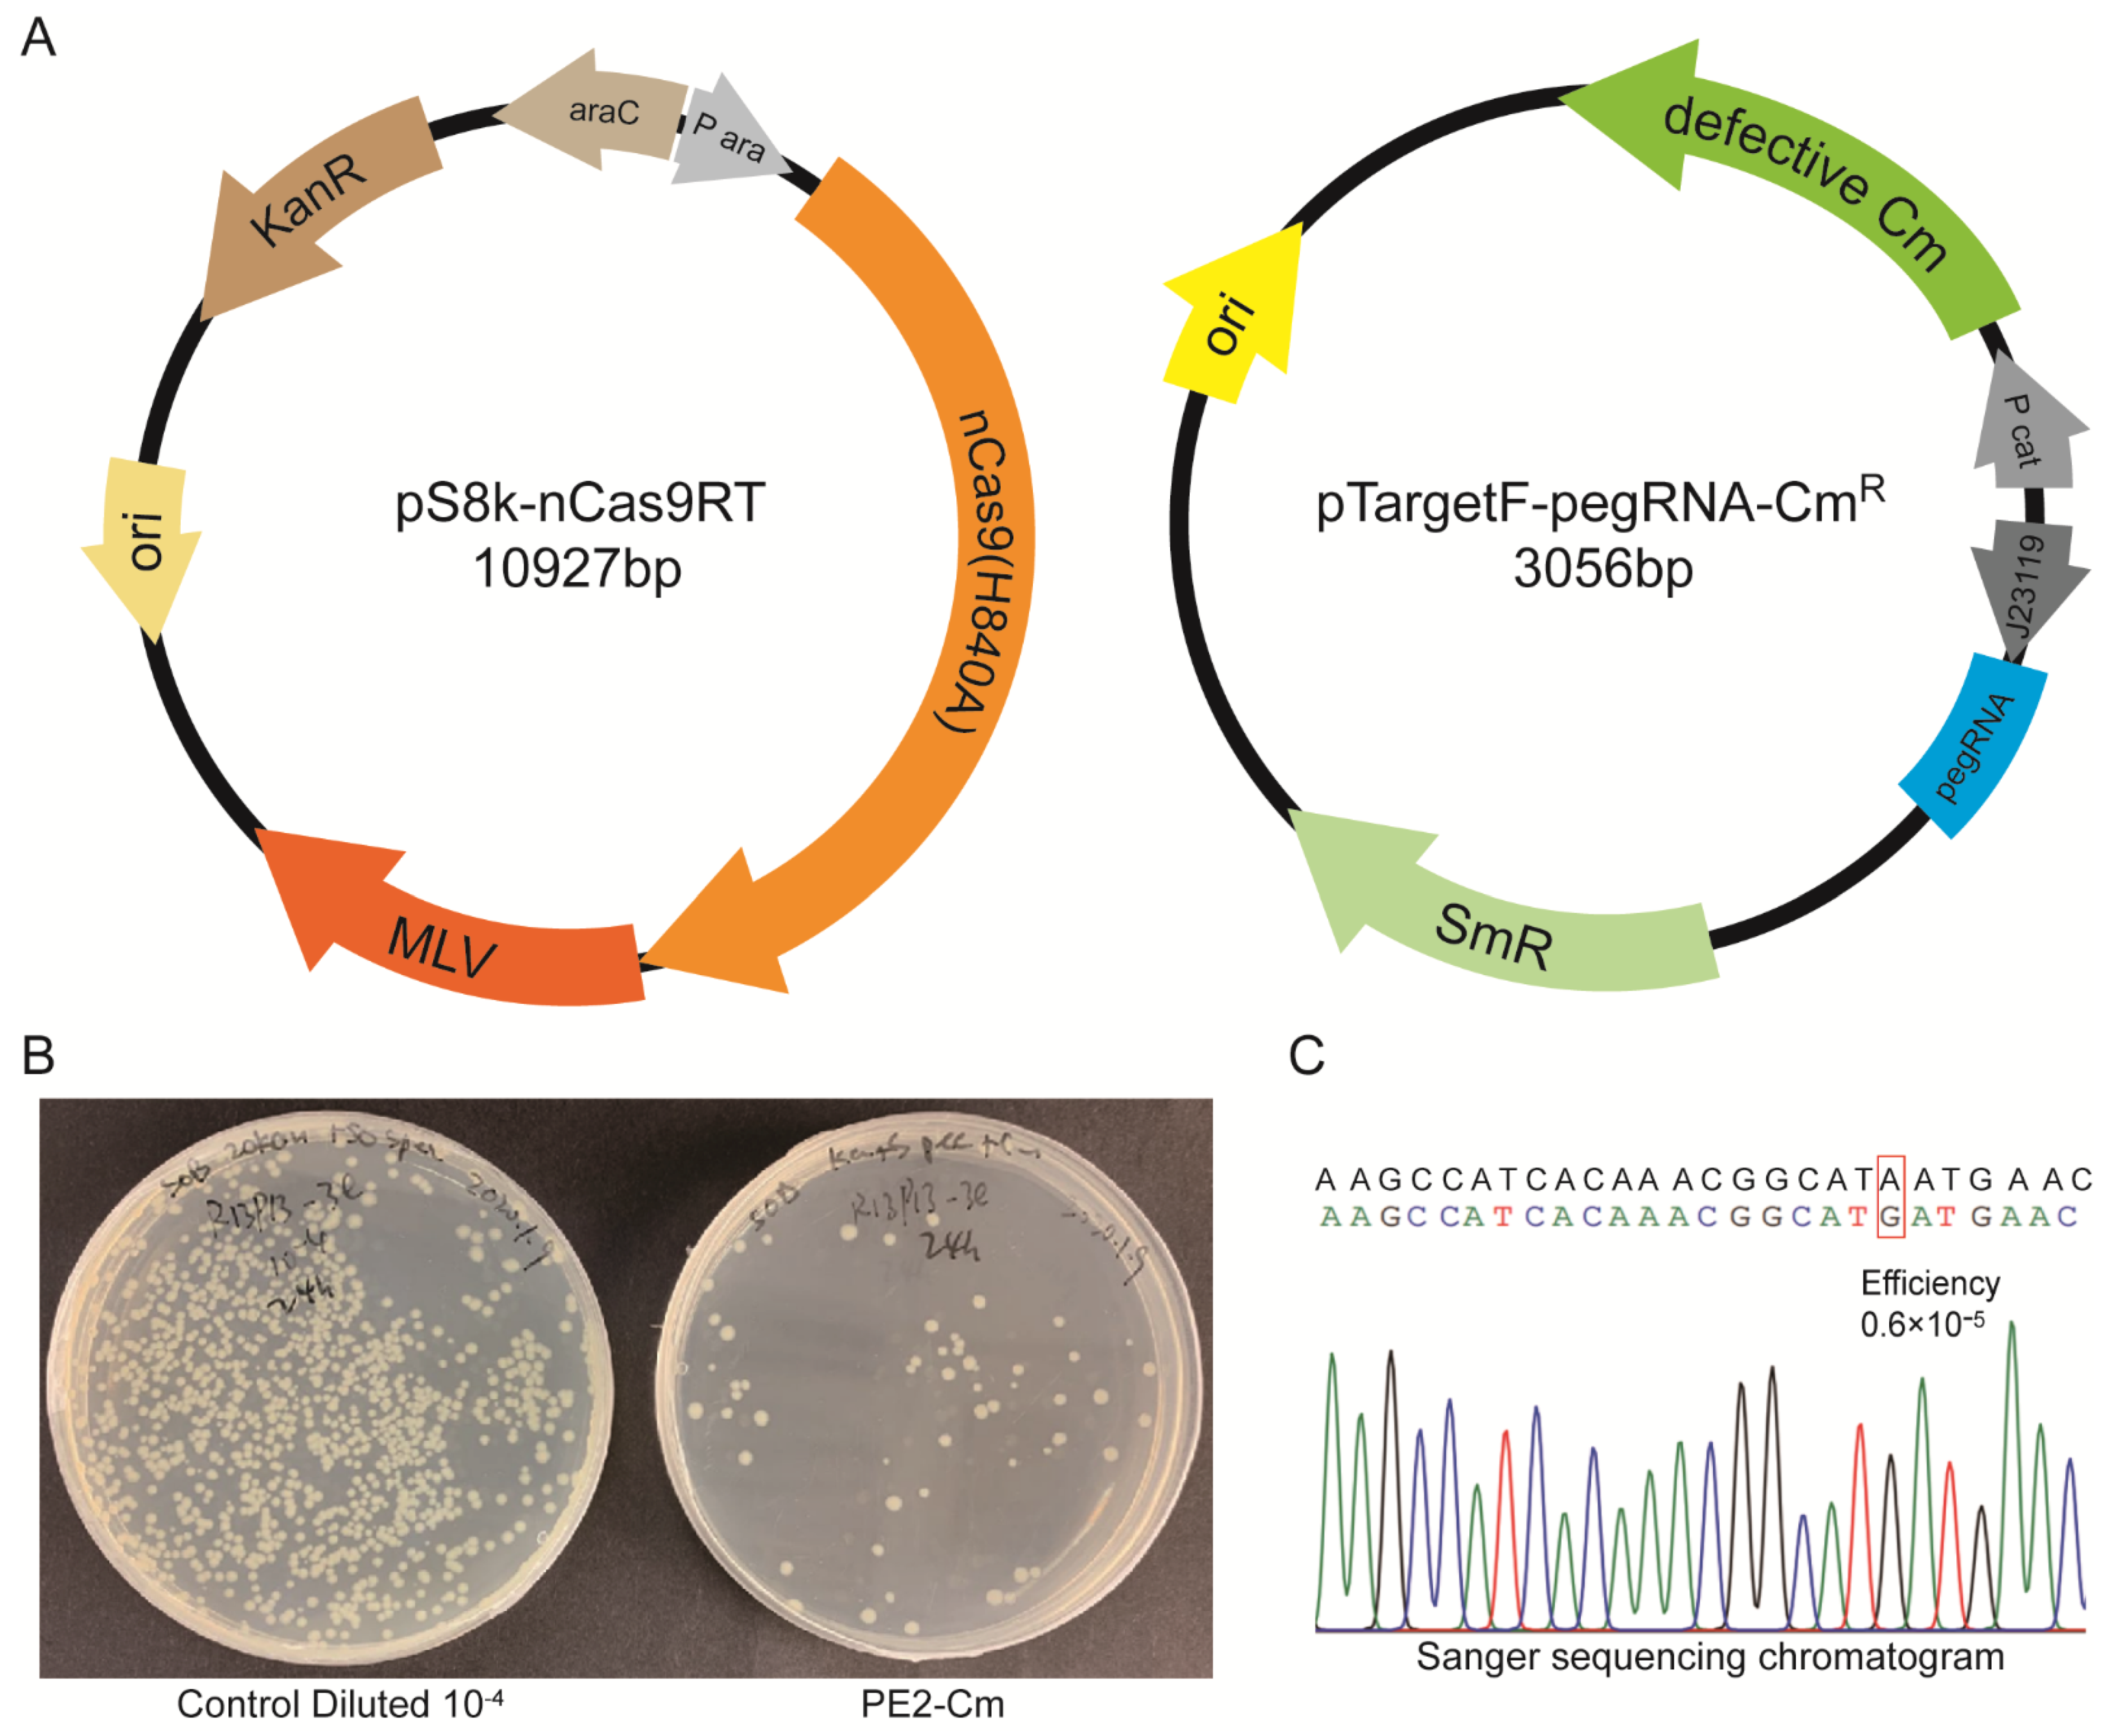
Molecules 27 01758 g002 550

Development and Optimization of CRISPR Prime Editing System in Photoautotrophic Cells
Abstract
:1. Introduction
2. Results
2.1. Development of Prime Editing in E. coli
2.2. Development of PE2 in Arabidopsis Cells
2.3. Optimization of PE2 in Arabidopsis Cells
2.4. nCas9(H840A) in PE2 Cause Indels
3. Discussion
4. Materials and Methods
4.1. Plasmid Construction
4.2. Efficiency Assay in E. coli
4.3. Protoplast Transfection
4.4. DNA Extraction and Amplicon Sequencing
Supplementary Materials
Author Contributions
Funding
Institutional Review Board Statement
Informed Consent Statement
Data Availability Statement
Acknowledgments
Conflicts of Interest
Sample Availability
References
- Hille, F.; Richter, H.; Wong, S.P.; Bratovic, M.; Ressel, S.; Charpentier, E. The Biology of CRISPR-Cas: Backward and Forward. Cell 2018, 172, 1239–1259. [Google Scholar] [CrossRef] [PubMed] [Green Version]
- Paquet, D.; Kwart, D.; Chen, A.; Sproul, A.; Jacob, S.; Teo, S.; Olsen, K.M.; Gregg, A.; Noggle, S.; Tessier-Lavigne, M. Efficient introduction of specific homozygous and heterozygous mutations using CRISPR/Cas9. Nature 2016, 533, 125–129. [Google Scholar] [CrossRef] [PubMed]
- Gaudelli, N.M.; Komor, A.C.; Rees, H.A.; Packer, M.S.; Badran, A.H.; Bryson, D.I.; Liu, D.R. Programmable base editing of A*T to G*C in genomic DNA without DNA cleavage. Nature 2017, 551, 464–471. [Google Scholar] [CrossRef]
- Komor, A.C.; Kim, Y.B.; Packer, M.S.; Zuris, J.A.; Liu, D.R. Programmable editing of a target base in genomic DNA without double-stranded DNA cleavage. Nature 2016, 533, 420–424. [Google Scholar] [CrossRef] [PubMed] [Green Version]
- Anzalone, A.V.; Randolph, P.B.; Davis, J.R.; Sousa, A.A.; Koblan, L.W.; Levy, J.M.; Chen, P.J.; Wilson, C.; Newby, G.A.; Raguram, A.; et al. Search-and-replace genome editing without double-strand breaks or donor DNA. Nature 2019, 576, 149–157. [Google Scholar] [CrossRef]
- Lin, Q.; Zong, Y.; Xue, C.; Wang, S.; Jin, S.; Zhu, Z.; Wang, Y.; Anzalone, A.V.; Raguram, A.; Doman, J.L.; et al. Prime genome editing in rice and wheat. Nat. Biotechnol. 2020, 38, 582–585. [Google Scholar] [CrossRef]
- Tang, X.; Sretenovic, S.; Ren, Q.; Jia, X.; Li, M.; Fan, T.; Yin, D.; Xiang, S.; Guo, Y.; Liu, L.; et al. Plant Prime Editors Enable Precise Gene Editing in Rice Cells. Mol. Plant 2020, 13, 667–670. [Google Scholar] [CrossRef]
- Li, H.; Li, J.; Chen, J.; Yan, L.; Xia, L. Precise Modifications of Both Exogenous and Endogenous Genes in Rice by Prime Editing. Mol. Plant 2020, 13, 671–674. [Google Scholar] [CrossRef]
- Xu, R.; Li, J.; Liu, X.; Shan, T.; Qin, R.; Wei, P. Development of Plant Prime-Editing Systems for Precise Genome Editing. Plant Commun. 2020, 1, 100043. [Google Scholar] [CrossRef]
- Xu, W.; Zhang, C.; Yang, Y.; Zhao, S.; Kang, G.; He, X.; Song, J.; Yang, J. Versatile Nucleotides Substitution in Plant Using an Improved Prime Editing System. Mol. Plant 2020, 13, 675–678. [Google Scholar] [CrossRef]
- Butt, H.; Rao, G.S.; Sedeek, K.; Aman, R.; Kamel, R.; Mahfouz, M. Engineering herbicide resistance via prime editing in rice. Plant Biotechnol. J. 2020, 18, 2370–2372. [Google Scholar] [CrossRef] [PubMed]
- Hua, K.; Jiang, Y.; Tao, X.; Zhu, J.K. Precision genome engineering in rice using prime editing system. Plant Biotechnol. J. 2020, 18, 2167–2169. [Google Scholar] [CrossRef] [PubMed]
- Wang, L.; Kaya, H.B.; Zhang, N.; Rai, R.; Willmann, M.R.; Carpenter, S.C.D.; Read, A.C.; Martin, F.; Fei, Z.; Leach, J.E.; et al. Spelling Changes and Fluorescent Tagging With Prime Editing Vectors for Plants. Front. Genome Ed. 2021, 3, 617553. [Google Scholar] [CrossRef] [PubMed]
- Jiang, Y.Y.; Chai, Y.P.; Lu, M.H.; Han, X.L.; Lin, Q.; Zhang, Y.; Zhang, Q.; Zhou, Y.; Wang, X.C.; Gao, C.; et al. Prime editing efficiently generates W542L and S621I double mutations in two ALS genes in maize. Genome Biol. 2020, 21, 257. [Google Scholar] [CrossRef] [PubMed]
- Lu, Y.; Tian, Y.; Shen, R.; Yao, Q.; Zhong, D.; Zhang, X.; Zhu, J.K. Precise genome modification in tomato using an improved prime editing system. Plant Biotechnol. J. 2021, 19, 415–417. [Google Scholar] [CrossRef] [PubMed]
- Patel, V.K.; Soni, N.; Prasad, V.; Sapre, A.; Dasgupta, S.; Bhadra, B. CRISPR-Cas9 System for Genome Engineering of Photosynthetic Microalgae. Mol. Biotechnol. 2019, 61, 541–561. [Google Scholar] [CrossRef]
- Lee, T.S.; Krupa, R.A.; Zhang, F.; Hajimorad, M.; Holtz, W.J.; Prasad, N.; Lee, S.K.; Keasling, J.D. BglBrick vectors and datasheets: A synthetic biology platform for gene expression. J. Biol. Eng. 2011, 5, 12. [Google Scholar] [CrossRef] [Green Version]
- Liu, Z.; Chen, O.; Wall, J.B.J.; Zheng, M.; Zhou, Y.; Wang, L.; Ruth Vaseghi, H.; Qian, L.; Liu, J. Systematic comparison of 2A peptides for cloning multi-genes in a polycistronic vector. Sci. Rep. 2017, 7, 2193. [Google Scholar] [CrossRef]
- Kang, B.C.; Yun, J.Y.; Kim, S.T.; Shin, Y.; Ryu, J.; Choi, M.; Woo, J.W.; Kim, J.S. Precision genome engineering through adenine base editing in plants. Nat. Plants 2018, 4, 427–431. [Google Scholar] [CrossRef]
- Clement, K.; Rees, H.; Canver, M.C.; Gehrke, J.M.; Farouni, R.; Hsu, J.Y.; Cole, M.A.; Liu, D.R.; Joung, J.K.; Bauer, D.E.; et al. CRISPResso2 provides accurate and rapid genome editing sequence analysis. Nat. Biotechnol. 2019, 37, 215–226. [Google Scholar] [CrossRef]
- Schmidt, F.; Cherepkova, M.Y.; Platt, R.J. Transcriptional recording by CRISPR spacer acquisition from RNA. Nature 2018, 562, 380–385. [Google Scholar] [CrossRef] [PubMed]
- Silas, S.; Mohr, G.; Sidote, D.J.; Markham, L.M.; Sanchez-Amat, A.; Bhaya, D.; Lambowitz, A.M.; Fire, A.Z. Direct CRISPR spacer acquisition from RNA by a natural reverse transcriptase-Cas1 fusion protein. Science 2016, 351, aad4234. [Google Scholar] [CrossRef] [PubMed] [Green Version]
- Gonzalez-Delgado, A.; Mestre, M.R.; Martinez-Abarca, F.; Toro, N. Spacer acquisition from RNA mediated by a natural reverse transcriptase-Cas1 fusion protein associated with a type III-D CRISPR-Cas system in Vibrio vulnificus. Nucleic Acids Res. 2019, 47, 10202–10211. [Google Scholar] [CrossRef] [PubMed]
- Zheng, Y.; Li, Q.; Ye, M.; Chen, A.; Wang, H. Applications of CRISPR/Cas9-based genome editing in the plant biology. Tur. J. Botany 2021, 45, 253–268. [Google Scholar] [CrossRef]
- Hassan, M.M.; Zhang, Y.; Yuan, G.; De, K.; Chen, J.G.; Muchero, W.; Tuskan, G.A.; Qi, Y.; Yang, X. Construct design for CRISPR/Cas-based genome editing in plants. Trends Plant Sci. 2021, 26, 1133–1152. [Google Scholar] [CrossRef]
- Lin, Q.; Jin, S.; Zong, Y.; Yu, H.; Zhu, Z.; Liu, G.; Kou, L.; Wang, Y.; Qiu, J.L.; Li, J.; et al. High-efficiency prime editing with optimized, paired pegRNAs in plants. Nat. Biotechnol. 2021, 39, 923–927. [Google Scholar] [CrossRef]
- Liu, Y.; Li, X.; He, S.; Huang, S.; Li, C.; Chen, Y.; Liu, Z.; Huang, X.; Wang, X. Efficient generation of mouse models with the prime editing system. Cell Discov. 2020, 6, 27. [Google Scholar] [CrossRef]
- Nelson, J.W.; Randolph, P.B.; Shen, S.P.; Everette, K.A.; Chen, P.J.; Anzalone, A.V.; An, M.; Newby, G.A.; Chen, J.C.; Hsu, A.; et al. Engineered pegRNAs improve prime editing efficiency. Nat. Biotechnol. 2021. [Google Scholar] [CrossRef]
- Rees, H.A.; Yeh, W.H.; Liu, D.R. Development of hRad51-Cas9 nickase fusions that mediate HDR without double-stranded breaks. Nat. Commun. 2019, 10, 2212. [Google Scholar] [CrossRef]
- Banerjee, S.; Banerjee, S.; Ghosh, A.K.; Das, D. Maneuvering the genetic and metabolic pathway for improving biofuel production in algae: Present status and future prospective. Renew. Sustain. Energy Rev. 2020, 133, 110155. [Google Scholar] [CrossRef]
- Jiang, W.; Brueggeman, A.J.; Horken, K.M.; Plucinak, T.M.; Weeks, D.P. Successful transient expression of Cas9 and single guide RNA genes in Chlamydomonas reinhardtii. Eukaryot. Cell 2014, 13, 1465–1469. [Google Scholar] [CrossRef] [PubMed] [Green Version]
- Lin, W.R.; Tan, S.I.; Hsiang, C.C.; Sung, P.K.; Ng, I.S. Challenges and opportunity of recent genome editing and multi-omics in cyanobacteria and microalgae for biorefinery. Bioresour. Technol. 2019, 291, 121932. [Google Scholar] [CrossRef] [PubMed]
- Yoo, S.D.; Cho, Y.H.; Sheen, J. Arabidopsis mesophyll protoplasts: A versatile cell system for transient gene expression analysis. Nat. Protoc. 2007, 2, 1565–1572. [Google Scholar] [CrossRef] [PubMed] [Green Version]

| Plasmid | Target Site | Aim | Average Efficiency | Average Proportion of NGS Reads with No Changes (%) |
|---|---|---|---|---|
| Non 1 | PDS3-1 | / | 0.0203% | 90 |
| pPE2-35SAt | PDS3-1 | +3 A to T | 1.1506% | 94.23 |
| pPE2-RPS5AAt | PDS3-1 | +3 A to T | 0.0342% | 58.05 |
| pPE2-UBQ10At | PDS3-1 | +3 A to T | 0.0194% | 77.89 |
| pPE3b-35SAt | PDS3-1 | +3 A to T | 0.0318% | 78.42 |
| pPE2-35SRat | PDS3-1 | +3 A to T | 0.1329% | 86.39 |
| pPE2-35SFs | PDS3-1 | +3 A to T | 0.0255% | 84.56 |
| pPE2-35SMm | PDS3-1 | +3 A to T | 0.0214% | 49.56 |
| pPE2-35SVv | PDS3-1 | +3 A to T | 0.0187% | 40.36 |
| pPE2-35SAt-NT | PDS3-1 | / | 0.0336% | 50.73 |
| Non 1 | PDS3-2 | / | 0.0997% | 93.39 |
| pPE2-35SAt | PDS3-2 | +5 G to A | 0.1167% | 92.83 |
| Non 1 | ALS-1 | / | 0.1369% | 93.47 |
| pPE3-35SAt | ALS-1 | +2 A to G | 0.1547% | 91.71 |
Publisher’s Note: MDPI stays neutral with regard to jurisdictional claims in published maps and institutional affiliations. |
© 2022 by the authors. Licensee MDPI, Basel, Switzerland. This article is an open access article distributed under the terms and conditions of the Creative Commons Attribution (CC BY) license (https://creativecommons.org/licenses/by/4.0/).
Share and Cite
Jiang, Z.; Abdullah; Zhang, S.; Jiang, Y.; Liu, R.; Xiao, Y. Development and Optimization of CRISPR Prime Editing System in Photoautotrophic Cells. Molecules 2022, 27, 1758. https://doi.org/10.3390/molecules27061758
Jiang Z, Abdullah, Zhang S, Jiang Y, Liu R, Xiao Y. Development and Optimization of CRISPR Prime Editing System in Photoautotrophic Cells. Molecules. 2022; 27(6):1758. https://doi.org/10.3390/molecules27061758
Chicago/Turabian StyleJiang, Zhengzheng, Abdullah, Shun Zhang, Yuli Jiang, Rui Liu, and Yi Xiao. 2022. "Development and Optimization of CRISPR Prime Editing System in Photoautotrophic Cells" Molecules 27, no. 6: 1758. https://doi.org/10.3390/molecules27061758
APA StyleJiang, Z., Abdullah, Zhang, S., Jiang, Y., Liu, R., & Xiao, Y. (2022). Development and Optimization of CRISPR Prime Editing System in Photoautotrophic Cells. Molecules, 27(6), 1758. https://doi.org/10.3390/molecules27061758

